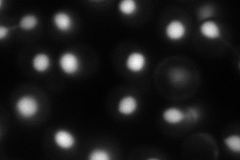
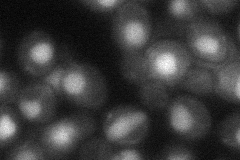

View description
DNA 3'-phosphatase that functions in repair of endogenous damage of double-stranded DNA, activity is specific for removal of 3' phosphates at strand breaks; has similarity to the l-2-haloacid dehalogenase superfamily
Localization:
Intensity:
Fold change:
Significance:
-
C’ GFP library in SD

below threshold18.07 -
N' NOP1pr-GFP in SD
nucleus111.136 -
N' TEF2pr-mCherry in SD

nucleus132.849 -
N' NATIVEpr-GFP in SD

punctate,nucleus20.1433 -
N' TEF2pr-VC and Cyto-VN in SD
nucleus39.9885 -
C’ GFP library in SD+DTT

cytosol16.40.9No -
C’ GFP library in SD+H2O2

cytosol13.380.74No -
C’ GFP library in Starvation Media

cytosol15.870.87No -
C’ GFP library on the background of Pup2-DaMP

below threshold -
C’ GFP library on the background of CCT mutant

below threshold17.94110.992005No
